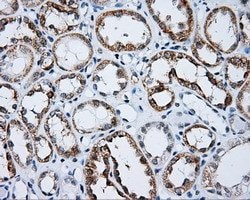
LIPG Monoclonal Antibody (OTI6B11), TrueMAB , OriGene 100 &mu;L; Unconjugated:Anticuerpos

missing translation for 'onlineSavingsMsg'
Learn More
Learn More
LIPG Monoclonal Antibody (OTI6B11), TrueMAB™, OriGene

Descripción
LIPG (Lipase G, Endohelial type) is an endothelial lipase which is a novel member of the lipoprotein lipase gene family. LIPG is synthesized by endothelial cells and functions at the site of synthesis. LIPG most likely plays a physiological role in modulating lipoprotein metabolism. Overexpressed LIPG has been shown to reduce HDL cholesterol levels, whereas an LIPG deficiency appears to be effective in elevating HDL cholesterol levels in animals. LIPG has substantial phospholipase activity and may be involved in lipoprotein metabolism and vascular biology. Also, LIPG is designated a member of the TG lipase family by its sequence and characteristic lid region which provides substrate specificity for enzymes of the TG lipase family. LIPG is a carboxyl esterase that hydrolyzes high density lipoproteins, emulsifies triglycerides, is essential for the efficient digestion of dietary fats and can bind to heparin.
Especificaciones
Especificaciones
| Antígeno | LIPG |
| Aplicaciones | Flow Cytometry, Immunocytochemistry, Immunofluorescence, Immunohistochemistry (Paraffin), Immunoprecipitation |
| Clasificación | Monoclonal |
| Clon | OTI6B11 |
| Concentración | 0.51 mg/mL |
| Conjugado | Unconjugated |
| Formulación | PBS with 1% BSA, 50% glycerol and 0.02% sodium azide |
| génica | LIPG |
| N.º de referencia del gen | Q9Y5X9 |
| Alias de gen | EDL, EL, PRO719 |
| Mostrar más |
Título del producto
Al hacer clic en Enviar, acepta que Fisher Scientific se ponga en contacto con usted en relación con los comentarios que ha proporcionado en este formulario. No compartiremos su información para ningún otro fin. Toda la información de contacto proporcionada se mantendrá de acuerdo con nuestra Política de Privacidad. Política de privacidad.
¿Detecta una oportunidad de mejora?